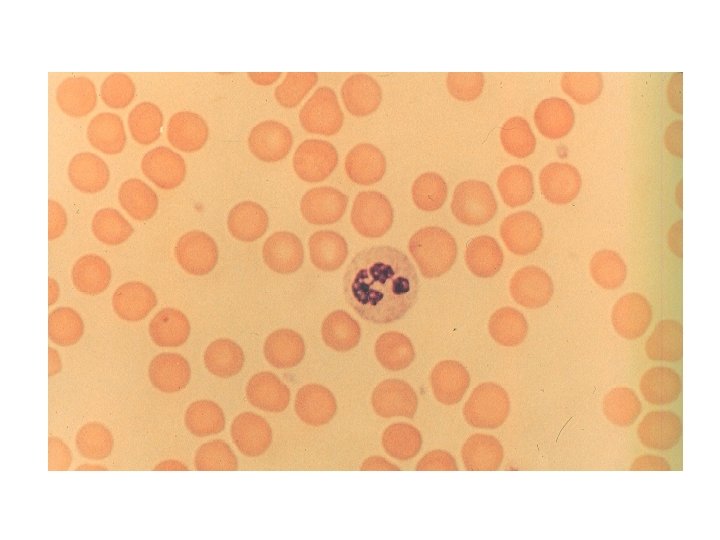

HISTOLOGY SLIDES SIMPLE SQUAMOUS EPITHELIUM SIMPLE CUBOIDAL EPITHELIUM

HISTOLOGY SLIDES

SIMPLE SQUAMOUS EPITHELIUM

SIMPLE CUBOIDAL EPITHELIUM

SIMPLE COLUMNAR

PSEUDOSTRATIFIED

STRATIFIED SQUAMOUS EPITHELIUM

BONE

BLOOD

CARDIAC MUSCLE

SKELETAL MUSCLE

SMOOTH MUSCLE

ADIPOSE

NERVOUS TISSUE

HYALINE CARTILAGE

FIBROCARTILAGE

DENSE REGULAR

LOOSE CONNECTIVE TISSUE (AREOLAR TISSUE)


Hyaline Cartilage • • • The type of cell that produces this tissue is Chondrocytes You would find this tissue End of bones, trachea rings, costal (ribs) Function of this tissue is Support and cushioning


Simple cuboidal epithelium • • This tissue would be found in Glands, ovaries and kidneys The function of this tissue is Secretion and absorption


Nervous Tissue • • Cells that support this tissue are called Neuroglia This tissue is found in the Brain, spinal cord and peripherial


Loose Connective Tissue or Areolar Tissue • • • The name of the yellow fibers Elastin This tissue would be found Under the skin The function of this tissue would be To attach skin to tissues and cushion organs


Cardiac Muscle • Found only in the • Heart

Blood • • This matrix of this tissue PLASMA The function of this tissue Transport gases, nutrients and waste


Pseudostratified Epithelium • • This tissue would be found in Respiratory tract and oviducts The function of this tissue would be To move materials along the outer surface of the cell.


Fibrocartilage • Tissue is found • In the intervertebral disc, hips and knee joints • The function is to absorb compressive shock.


Skeletal Muscle • This tissue is found in the body • Attached to bones


Simple squamous epithelium • • In the body this tissue Line or covers most abdominal organs The function of this type of tissue Allows for quick diffusion and to reduce friction


Bone • • • Cell that produces this tissue Osteocytes This tissue would be found in the Skeleton The function of this tissue is to Support, attachment sites, levers for movement and mineral storage


Smooth Muscle • This tissue is found in the body in the • Walls of hollow organs


Adipose Tissue • This tissue would be found in the body • Under skin, behind eyes, around kidneys, abdominal membranes • The function of this tissue is to • Insulate, pad and as a heat energy reserve • Substance stored in this tissue is • Fat


Dense Regular (collagenous) Fibers • • The white fibers found in this tissue are Collagen fibers You would find this tissue in the body Tendons, ligaments, white part of the eye


Simple columnar epithelium • • This tissue would be found in The lining of the digestive tract (stomach) The function of this tissue would be to Protect, absorb and sucrete


Stratified squamous epithelium • • • The protein that makes this tissue tough is Keratin Found in The lining of the mouth, anus, vagina The function To sucrete and protect
- Slides: 49